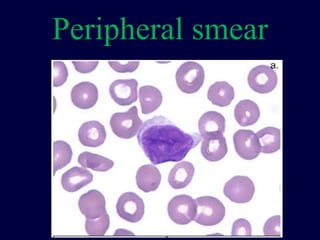
Peripheral smear

1) Acute leukemia is a type of cancer that affects the blood and bone marrow with two main types - acute lymphoblastic leukemia (ALL) and acute myeloid leukemia (AML).
2) ALL is more common in children between ages 2-5 years old and comprises 30% of all childhood cancers. The causes are unclear but some studies link it to environmental exposures and immune response to infections.
3) Diagnosis involves blood tests, peripheral smear, bone marrow aspirate and biopsy to examine cells for abnormalities. Risk classification is determined based on factors like age, white blood cell count, and genetics to guide treatment.